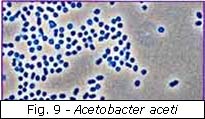

|
Introdução Sistemas de Classificação Desde tempos remotos, o Homem sentiu necessidade de organizar o mundo que o rodeava, ordenando e classificando a grande diversidade de seres vivos que com ele partilha o planeta. Na actualidade encontram-se classificadas cerca de 2 milhões de espécies. O Ramo da Biologia que se dedica à identificação dos grupos de seres vivos e respectiva nomenclatura, segundo critérios definidos, designa-se de Taxonometria.
Se compararmos as
características de diferentes seres vivos, de forma a definir a sua
linha evolutiva, entramos no campo da Sistemática, ou seja, da
Biologia Comparativa. A Sistemática engloba dados da Taxonometria e
da Biologia Evolutiva, para tentar compreender a história evolutiva dos
organismos e as suas relações de parentesco. O sistema de classificação de Lineu, sendo um sistema hierárquico, dividiu os seres vivos de acordo com categorias taxonómicas com diferentes extensões. A categoria taxonómica mais abrangente é o Reino, que se subdivide em categorias progressivamente menos abrangentes. O Reino subdivide-se em Filos (ou Divisões no caso de tratar de uma subdivisão do Reino Plantae), cada Filo em Classes, cada Classe em Ordens, cada Ordem em Famílias e cada Família em Géneros. No fim da cadeia das categorias taxonómicas, encontramos o menor grupo, que é a unidade básica da classificação: a Espécie. Um pouco de História Aristóteles estabeleceu sistemas de classificação racionais baseados em características estruturais dos seres vivos. Considerou apenas dois reinos: o Reino Animal (Animalia) e o Reino Vegetal (Plantae).
Carl Lineu
desenvolveu
um dos primeiros sistemas de classificação com um grau de estruturação
assinalável. Estes sistemas, apesar de terem evoluído
Haeckel estabeleceu um 3º reino de seres vivos: o Reino Protista. Neste reino inclui as algas, os protozoários e as bactérias. Copeland introduziu o Reino Monera, surgindo o sistema de classificação em quatro reinos. O Reino Monera é constituído por seres vivos que têm uma organização celular procariótica Em 1969, Whittaker propôs um sistema de classificação em cinco reinos, no qual os fungos passam a constituir um reino independente: Reino Fungi. Whittaker, ao classificar os seres vivos, apoiou-se no seu nível trófico e organização estrutural.
Mas, como todos os sistemas de classificação, o de Whittaker também apresenta algumas limitações, indicadas pelo próprio autor. Em 1979, Whittaker apresenta uma visão modificada do seu sistema de cinco reinos. Desta forma, o grupo de Protistas começou a incluir fungos flagelados, algas unicelulares e multicelulares.
Resumindo, Whittaker, no seu sistema de classificação dos seres vivos, considerava a existência de cinco reinos: . Reino Animalia; . Reino Plantae; . Reino Fungi; . Reino Protista; . Reino Monera. Reino Monera Os seres vivos do Reino Monera são unicelulares e procariontes. Estes organismos (bactérias e cianobactérias) adaptam-se a qual que tipo de habitat, incluindo alguns que nem suportam outra formas de vida. As bactérias têm dimensões muito reduzidas (1 a 5 micómetros, em média), podendo apresentar formas muito distintas: . Cocos (esféricos); . Bacilos (forma de bastonete); . Vibriões (forma de agulha); . Espirilos (espiralados).
Os procariontes possuem
células muito simples, sem organelos membranares. Estes organismos podem
possuir uma parede celular ou ai Os organismos do Reino Monera desempenham várias actividades com efeitos benéficos para outros seres vivos, mas a sua acção também pode ser bastante prejudicial em alguns casos. Fermentação As células de todos os seres vivos realizam um conjunto de reacções químicas essenciais à vida. Ao conjunto dessas reacções chama-se metabolismo celular. Existem duas reacções metabólicas diferentes: catabolismo e anabolismo. O catabolismo é uma reacção em que os compostos orgânicos são degradados em moléculas mais simples, ocorrendo libertação de energia. Por seu lado, o anabolismo consiste em reacções que formam moléculas mais complexas a partir de moléculas mais simples. As células obtêm energia através de uma série de reacções em cadeia, na qual as substâncias orgânicas vão sendo lentamente degradadas. Como a energia não pode ser utilizada directamente nas actividades celulares, esta é armazenada em compostos intermédios como o ATP. É através de vias catabólicas, como a fermentação e a respiração aeróbia, que a energia é transferida dos compostos orgânicos para as moléculas de ATP. Dependendo do aceptor final da reacção, podemos estar perante respiração ou fermentação. A fermentação é o processo mais primitivo de obtenção de matéria e compreende duas etapas: . Glicólise – reacções que degradam a glicose até piruvato; . Redução do piruvato – reacções que conduzem à formação dos produtos da fermentação. A redução do piruvato pode conduzir à formação de diferentes produtos. Deste modo, de acordo com o produto final, existem vários tipos de fermentação. Fermentação acética
No seu livro (“Tratado de
química Elementar”), o químico francês Lavoisier
Foi Pasteur que
veio a mostrar que sem a participação da
A fermentação acética corresponde à transformação do álcool em ácido acético por determinadas bactérias, conferindo o gosto característico de vinagre. Inicialmente, as bactérias acéticas foram designadas por Micoderma vini. Depois, em relação ao aspecto morfológico, foram classificadas em três espécies: Bacterium aceti, Bacterium pasteurianum e Bacterium kurtzingianus. Em 1898 foram classificadas como sendo do género Acetobacter. Pela classificação actual, as bactérias acéticas pertencem à família Pseudomonodaceae; aos géneros Acetobacter e Gluconobacter. As principais espécies de bactérias acéticas são: Acetobacter aceti, Acetobacter pasteurianus, Acetobacter xylinum, Acetobacter schützenbachii e Gluconobacter oxydans.
As principais espécies de Acetobacter, utilizadas na produção de vinagre, apresentam-se nas formas de bacilos e cocos, formando correntes e filamentos. As bactérias acéticas necessitam do oxigénio do ar para realizarem a acetificação. Por isso multiplicam-se mais na parte superior do vinho que está a ser transformado em vinagre, formando um véu conhecido como "mãe do vinagre". Esse véu pode ser mais ou menos espesso de acordo com o tipo de bactéria. Os objectivos estabelecidos para esta actividade experimental foram: . Observar e identificar microscopicamente as bactérias de vinagre; . Aprender e realizar novas técnicas de citologia; . Relacionar os conhecimentos anteriores com esta actividade; . Utilizar e desenvolver as técnicas de microscopia; . Familiarização ao meio laboratorial. Material utilizado . Microscópio; . Lâminas; . Pinça de madeira; . Tina de coloração; . Lamparina; . Fósforos; . Papel de filtro; . Papel de limpeza; . Solução de azul-de-metileno; . Óleo de Imersão; . Xilol; . Água; . Frasco lavador; . Vinho fermentado (vinagre). Métodos 1. Retire um pouco da película fina formada à superfície do vinho.
2. Espalhe o material na
lâmina, utilizando a técnica do esfreg 3. Seque o esfregaço ao ar durante alguns minutos. 4. Fixe o esfregaço pelo calor, passando 3 vezes a face inferior na chama da lamparina. 5. Coloque a lâmina na tina de coloração, sobre as duas varetas de vidro, e inunde o esfregaço com o corante. Deixe actuar a solução de azul-de-metileno durante 1 a 2 minutos. 6. Remova o corante do esfregaço por imersão em água, ou colocando a lâmina paralelamente ao fio de água do frasco lavador. 7. Retire, cuidadosamente, o excesso de água com papel de filtro. 8. Seque ao ar a zona do esfregaço. 9. Sem colocar lamela, coloque a lâmina no microscópio e proceda à sua focagem com uma das objectivas de menor ampliação. 10. Coloque uma gota de óleo de imersão sobre o esfregaço e observe com a objectiva de 100x. 11. Faça um esquema legendado do que observa. Resultados Os resultados da actividade foram registados numa folha branca. A folha onde ficaram registadas as minhas observações encontra-se em anexo. A imagem refere-se a uma observação microscópica, com uma ampliação de 1000x, a bactérias Acetobacter aceti num meio de montagem com azul-de-metileno. Discussão Para uma melhor compreensão da actividade laboratorial é necessário uma melhor compreensão de alguns procedimentos. Seguindo as etapas da actividade vou focar os seguintes temas: . Técnica de Esfregaço; . Técnica de Fixação; . Coloração; . Óleo de Imersão. A técnica de esfregaço é uma técnica muito simples e bastante usada em bacteriologia. Consiste em fazer deslocar uma lâmina sobre outra que contenha uma gota de material a observar na extremidade. Esta técnica citológica permite a obtenção de uma camada muito fina e homogénea de células sobre a lâmina. Após a secagem, o material pode ser fixado e corado.
Depois desta técnica, fixamos o esfregaço. A técnica de fixação tem por objectivo conservar, com o mínimo de artifícios, a estrutura que a célula tinha in vivo. A fixação pode ser feita por processos químicos, recorrendo ao uso de fixadores, substâncias químicas (metanol, etanol e outras) ou por processos físicos (por exemplo, o calor ou o frio. Durante esta actividade, fixamos o material através de um processo físico. Para fixar o material utilizamos a corrente de ar quente resultante da chama de uma lamparina e também ao calor ambiental. Não foi necessário o uso de lamelas nesta actividade devido à técnica de fixação. A técnica de coloração é utilizada sempre que se quer pôr em evidência certas estruturas celulares. Como ao MOC só é possível observar um corpo não corado se o seu índice de refracção for diferente do meio em que se encontra, usamos um corante. Ao usarmos o corante, pretendemos aumentar o contraste e distinguir regiões com igual nível de refracção. As substâncias que usamos criaram diferenças no grau de absorção de luz das células e dos seus organitos. Alguns corantes são selectivos pois coram especialmente um determinado organito. Existem dois diferentes métodos de coloração. Quando se aplica mais do que um corante, estamos perante um caso de coloração diferencial. Na coloração de Gram, o esfregaço bacteriano é inundado numa série predefinida de soluções: 1. Corante básico (solução de violeta-de-cristal ou violeta-de-genciana); 2. Mordente (solução de Lugol) – substância usada para fixar e intensificar a cor do primeiro corante; 3. Agente descorante (solução de álcool ou acetona); 4. Agente contrastante (solução de safranina ou fucsina de Ziehl).
Quando utilizamos um único corante, estamos a usar um método de coloração simples. Durante esta actividade utilizamos a coloração simples com azul-de-metileno. Este corante cora preferencialmente o núcleo com uma cor azul. Nota: Utilizamos a coloração simples pois a escola não dispunha das soluções necessárias para a realização da coloração de Gram. No fim da actividade utilizamos óleo de imersão para uma melhor observação no MOC ao usar a objectiva de 100x. O papel do óleo de imersão é focar uma maior quantidade de luz no locar observado. Posteriormente, utilizamos xilol para limpar a objectiva que esteve em contacto com o óleo. Conclusão A actividade laboratorial foi muito importante e benéfica pois conseguimos aprofundar os nossos conhecimentos da matéria leccionada recentemente. Para além do relacionamento desta actividade com os sistemas de classificação dos seres vivos, também utilizamos conhecimentos de matéria do 10º ano – fermentação. A actividade também possibilitou a aprendizagem de novos métodos laboratoriais, expandindo os nossos conhecimentos. Todos os objectivos propostos para esta actividade foram cumpridos, apesar da falta de concentração e distracção de alguns alunos. Por este motivo, a actividade foi bem sucedida e apoio a realização de mais actividades práticas laboratoriais. Bibliografia . www.e-escola.pt . www.escolavirtual.pt . www.notapositiva.com . www.wikipedia.org . Imagens retiradas do banco de imagens de www.google.pt . MATIAS, O; MARTINS, P. (2004). BIOLOGIA 11, Areal Editores, Porto Nota: A fotografia presente na capa do Relatório foi tirada pela colega Ana Marta Crespo, à qual agradeço.
Outros Trabalhos Relacionados
|
|



 e
de se terem diversificado, mantêm intacto a hierarquizaram proposta por
Lineu.
e
de se terem diversificado, mantêm intacto a hierarquizaram proposta por
Lineu.

 nda
uma cápsula espessa, que lhes conferem a forma característica, dando
suporte e protecção à célula.
nda
uma cápsula espessa, que lhes conferem a forma característica, dando
suporte e protecção à célula. escreveu que o vinagre não era nada mais que o vinho acetificado devido
à absorção do oxigénio, sendo portanto o resultado apenas de uma reacção
química. Pensava-se que a camada gelatinosa que se formava na superfície
do vinho em acetificação era apenas um produto da transformação, mas não
a causa.
escreveu que o vinagre não era nada mais que o vinho acetificado devido
à absorção do oxigénio, sendo portanto o resultado apenas de uma reacção
química. Pensava-se que a camada gelatinosa que se formava na superfície
do vinho em acetificação era apenas um produto da transformação, mas não
a causa.  bactéria
acética não há formação do vinagre. Assim, provou o papel de grande
relevo que as bactérias acéticas têm quando o vinho se transforma em
vinagre. Pasteur verificou que os substratos não se acetificavam em
contacto com o ar, através da oxidação directa, mas sim através da
participação das bactérias acéticas.
bactéria
acética não há formação do vinagre. Assim, provou o papel de grande
relevo que as bactérias acéticas têm quando o vinho se transforma em
vinagre. Pasteur verificou que os substratos não se acetificavam em
contacto com o ar, através da oxidação directa, mas sim através da
participação das bactérias acéticas.
aço.
aço.
